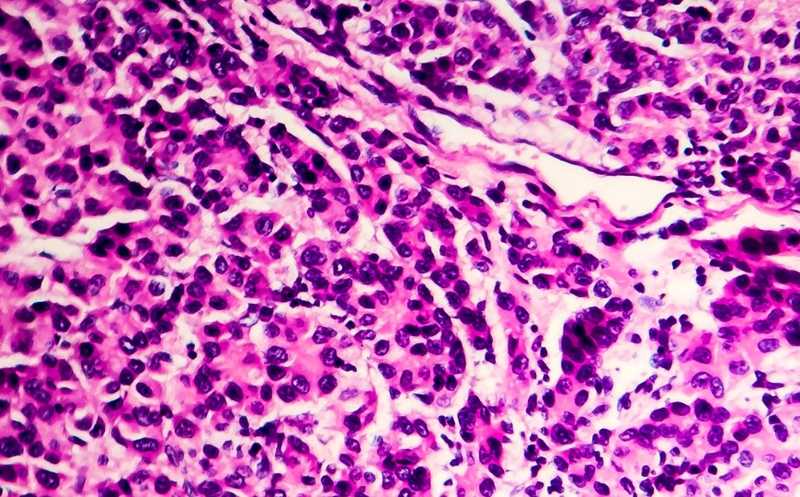

Авторизация
Регистрация
Я принимаю условия Пользовательского соглашения и даю своё согласие на обработку моей персональной информации на условиях, определенных Политикой конфиденциальности.


 Меню
Меню





 Все темы
Все темы